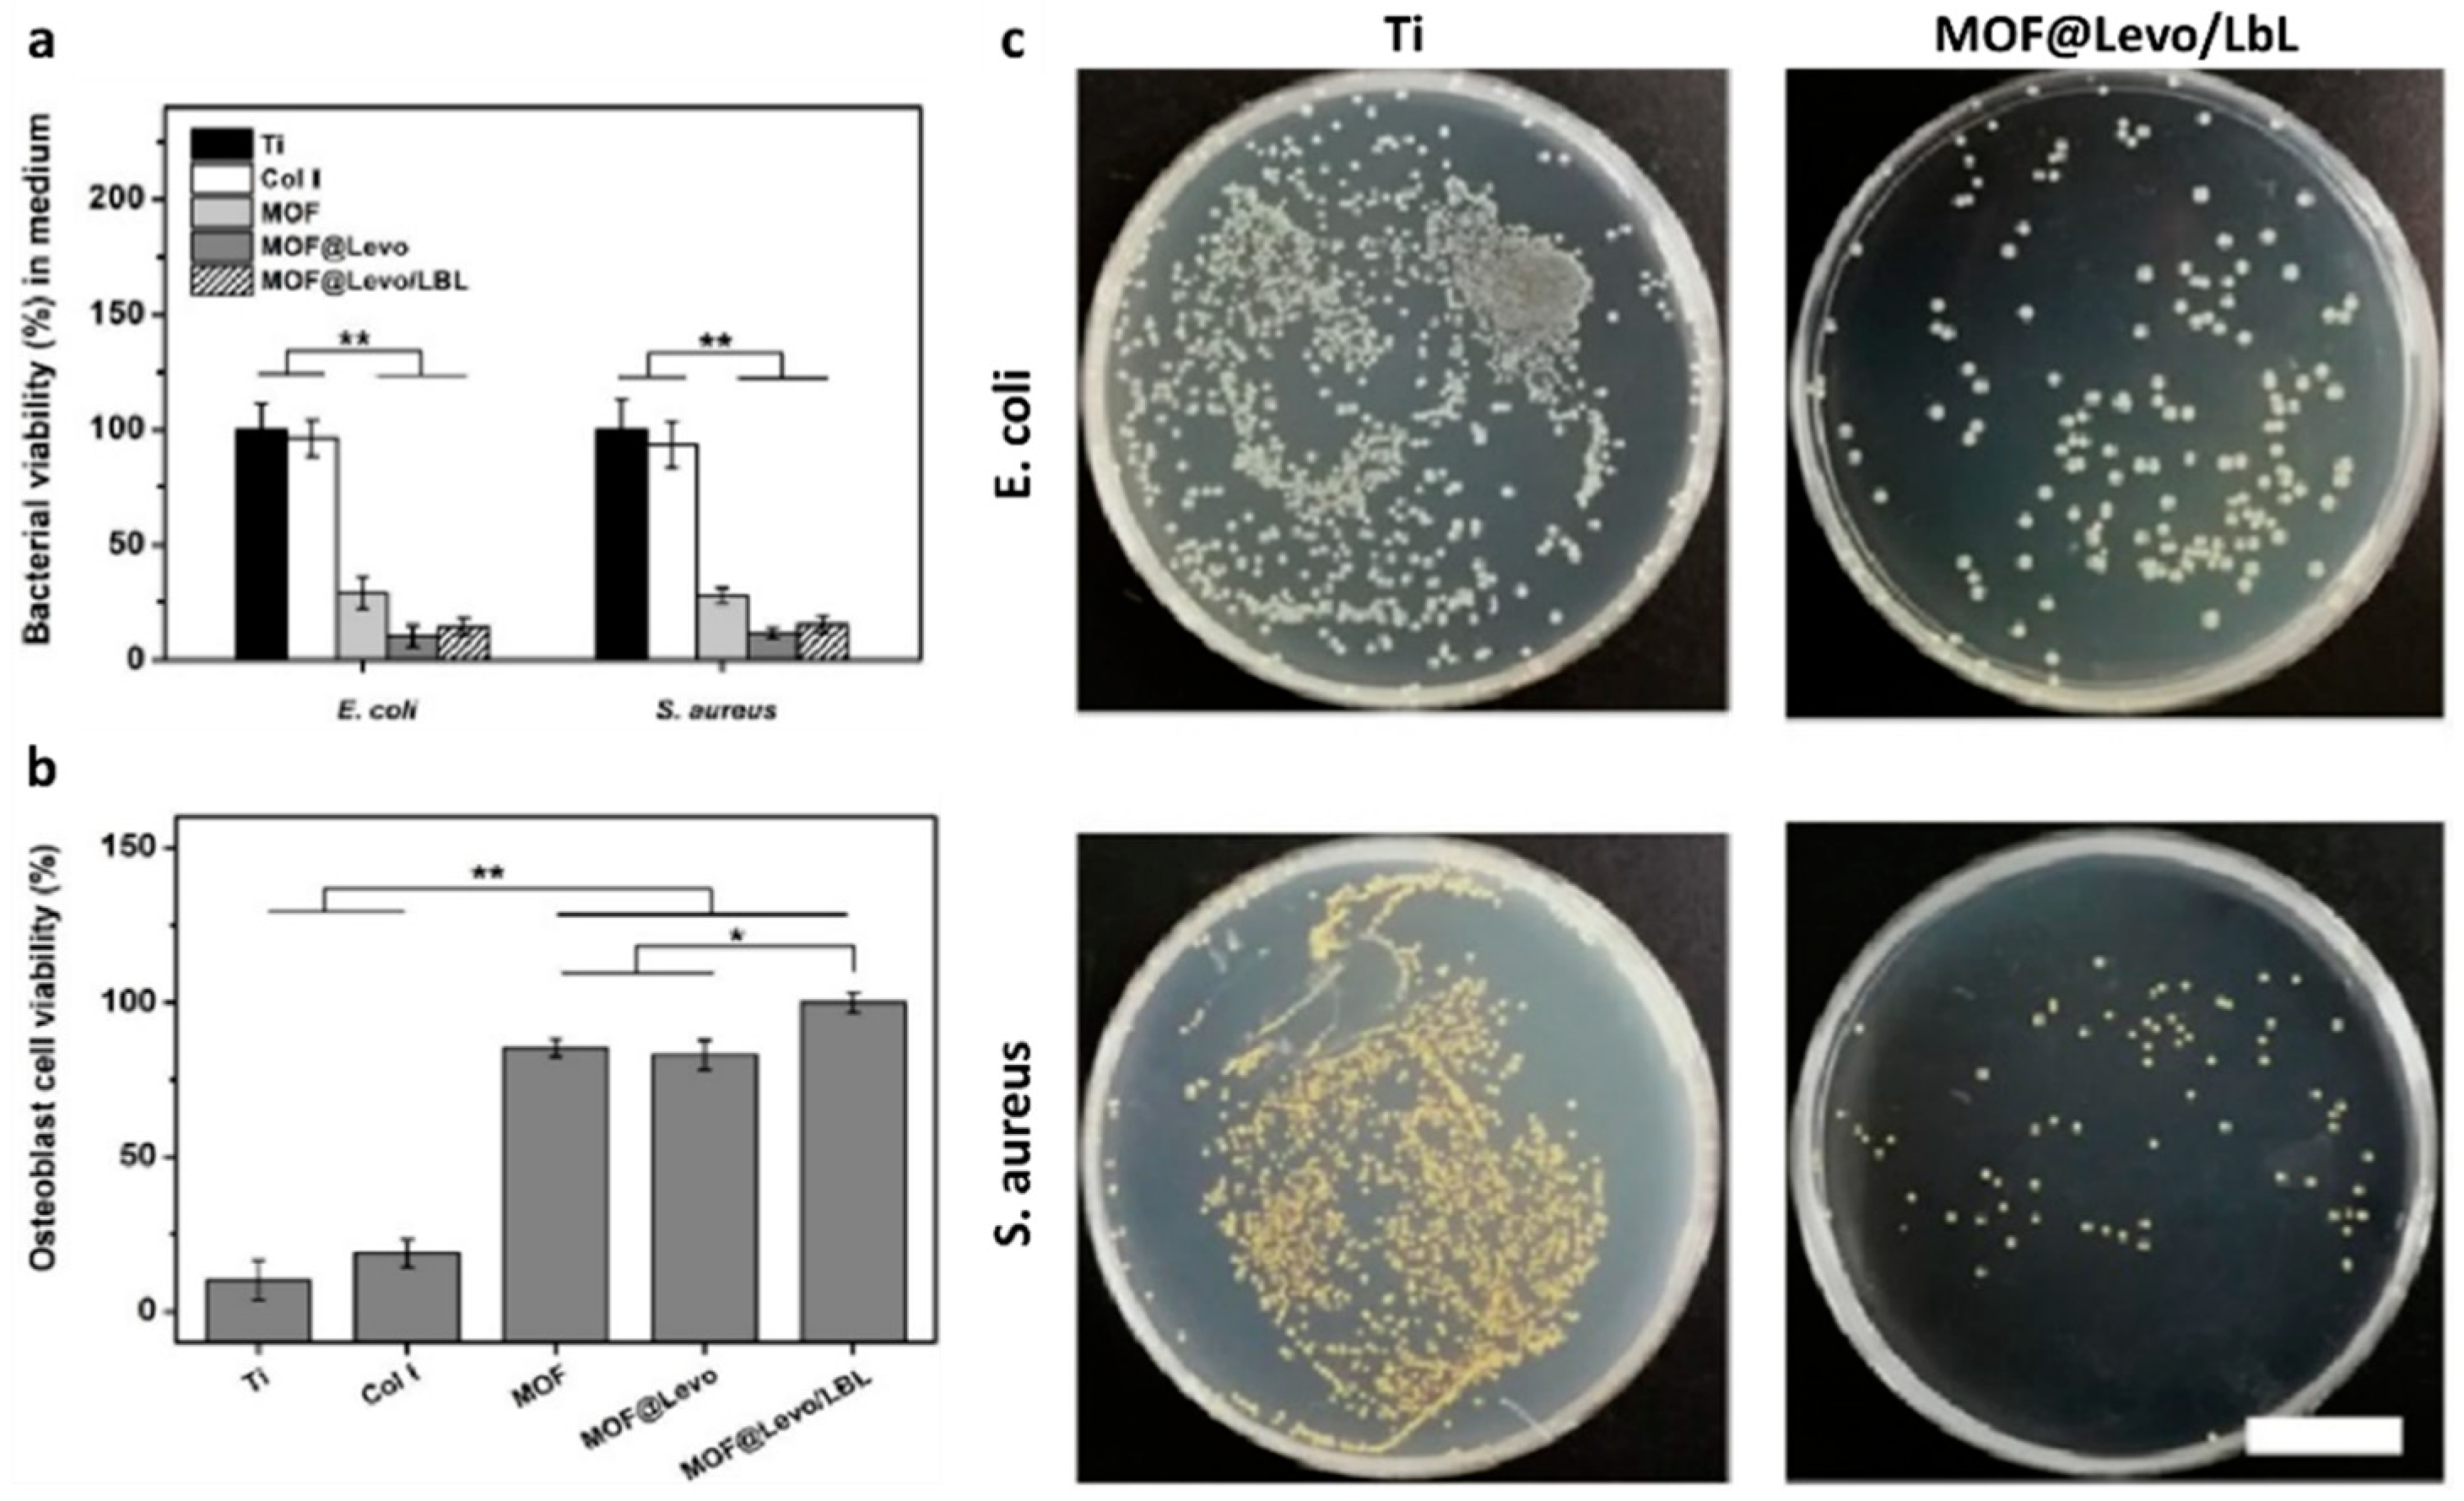
Polymers 13 01556 g005

Trends in Managing Cardiac and Orthopaedic Device-Associated Infections by Using Therapeutic Biomaterials
Abstract
1. Introduction
- Passive antifouling surface modifications;
- Active antimicrobial surface modifications;
- Peri-operative antimicrobial local carrier and coatings [13].
- Modifying implants’ surface chemistry (i.e., wettability, surface energy, potential, and conductivity);
- Modifying implants’ surface topography (i.e., crystallinity, roughness);
- Functionalizing implants’ surface with bactericidal agents-loaded coatings (i.e., metal ions, antiseptics or organic molecules, antibiotics) [13].
2. Causative Agents Involved in Cardiac and Orthopaedic Device-Associated Infections
2.1. Cardiac Device-Associated Infections
2.1.1. Infections in the New Cardiac Platform
2.1.2. Cardiac Implantable Electronic Devices
| First Author/ Year/ Type of Study | Total Number | TAVR Model | Type of Material | No. of TAVR-IE Patients | Yr. Incidence of TAVR-IE | Microbiology | Finding | Ref |
|---|---|---|---|---|---|---|---|---|
| Makkar 2020 Lancet RCT | 750 | † Portico, * SAPIEN, SAPIEN XT, SAPIEN 3, * CoreValve, Evolut-R, Evolut-PRO | Porcine-L/Nitonol-S Bovine-L/CrCo-S | - | - | - | Not designed to detect endocarditis | [29] |
| Lanz 2019 Lancet RCT | 739 | γACURATE neo, SAPIEN 3 | Porcine-L/Nitinol-S Bovine-L/CrCo-S | 3 at 30 days | NA | NA | Similar rates of IE between ACURATE neo and SAPIEN 3. Superiority of SAPIEN 3 for early safety and efficacy | [32] |
| Mack 2019 NEJM RCT | 496 | SAPIEN 3 | Bovine-L/CrCo-S | - | - | - | Not designed to detect endocarditis | [30] |
| Regueiro 2016 JAMA Retrospective | 20006 | CoreValve System SAPIEN | Porcine-L/Nitinol-S Bovine-L/CrCo-S | 250 at 1 y | 1.1% | Enterococci (24.6%), S. aureus (3.8%), CoNS | IE associated with younger age, male sex, history of diabetes, moderate to severe residual aortic regurgitation IE patients had high rates of in-hospital mortality and 2-year mortality | [28] |
| Mangner 2016 JACC OS | 1820 | CoreValve System | Porcine-L/Nitinol-S | 55 at 1 y | 1.82% | CoPS (38.2%), MRSA and Enterococci (30.9%), CoNS (9.1%) | Patients in chronic hemodialysis at highest risk group for development and death by IE. Poor prognosis of IE patients | [40] |
3. Orthopaedic Device-Associated Infections
4. Biofilm Formation Process
4.1. Bacteria Adhesion
4.2. Biofilm Maturation
4.3. Biofilm Spreading
4.4. Antibiotic Resistance in Biofilms
5. Common Standard Treatments Used in the MDIs Management
6. Passive and Active Antibiofilm Treatments
6.1. Passive Antifouling Strategies in cDAIs and oDAIs
6.2. Active Antimicrobial Strategies in cDAIs and oDAIs
7. Promising Antimicrobial Compounds for the Treatment of Cardiac and Orthopaedic Device-Associated Infections
| Material | Functionalization Treatment | Physico-Chemical Features | In Vitro Response | In Vivo Response | Ref. |
|---|---|---|---|---|---|
| Passive antifouling strategies | |||||
| Ti6Al4V wires | UV-C irradiation | θ = 12° | S. aureus adhesion reduction (70.48%) Osteointegration at 4 weeks | [69] | |
| pSBM-grafted Ti6Al4V pins | Surface-initiated polymerization | θ = 10° | Xen-29 S. aureus adhesion and colonization reduction | Xen-29 S. aureus colonization suppression in infected mouse femoral canal at 21 days, with a systemic VAN injection at day 7 | [70] |
| PEG-coated Ti disks | Pulsed electrodeposition | θ < 5° | S. aureus and E. coli adhesion reduction (90%) Human fibroblast adhesion supporting | [71] | |
| Quercitrin-grafted Ti6Al4V implant | Wet chemistry | Pore size 500 µm Porosity 52% E = 5.58 ± 0.3 GPa | S. epidermidis adhesion reduction (75%) Osteoinductive properties | [72] | |
| NDs-coated Ti plates | Dip-coating | θ decreased by increases NDs concentration | S. aureus adhesion reduction (88%) Human dermal fibroblasts (32%) and Osteoblasts (29%) proliferation at 3 days | [73] | |
| Active antimicrobial strategies | |||||
| Rod-/Cube-/Octa-CeO2-coated Ti disks | Spin coating | θ ≈ 37–38° | Saliva-protein repellent activity Anti-inflammatory effects and ROS-scavenging ability S. sanguinis early adhesion and colonization inhibition P. gingivalis biofilm formation reduction at 4 days | Anti-inflammatory effect in an in vivo rat model | [76] |
| CeO2-doped HA/Coll coated Ti plate | Biomimetic wet chemistry | E. coli (92.61%) and S. aureus (73.59%) bactericidal effect at 24 h | [77] | ||
| Se NPs-coated Ti plates and screws | Surface-induced nucleation-deposition | Se NPs size 30–70 nm | Biofilm formation and associated local contamination inhibition MRSA and MRSE bacteria pre-inoculated in rat femurs implants | [78] | |
| PLGA/HA/HACC scaffold | Covalent grafting | σCompr ≈ 31.3 ± 0.5 MPa σTensile ≈ 21.5 ± 0.6 MPa E ≈ 1.9 ± 0.2 GPa | Antimicrobial and osteoconductive properties | Low bacteria burden (at 8 weeks) and new bone formation (at 4 weeks) in femoral shaft and condyle collected in rats and rabbits in vivo animal model | [80] |
| pDEMMP15-b-pTMAEMA70-coated TC4 plate | Covalent binding | θ ≈ 39.5 ± 7.3° | S. aureus (95.8%) and E. coli (92.9%) cells adhesion reduction | [83] | |
| (Q-PVP)-Ti plates | Spin-/Dip-coating | Suitable bactericidal effect against MRSA and biocompatibility toward fibroblast and osteoblast-like cells | [84] | ||
| VAN-loaded niosomes coated stainless steel plates | Dip-coating | Niosomes: Size ≈ 340.5 ± 2.95 nm ξ ≈ −45.4 ± 0.77 mV EE ≈ 50.47 ± 3.66% DL ≈ 19 ± 1.77% | VAN MIC ≈ 8 µg/mL vs. S. aureus VAN MBC ≈ 125 µg/mL vs. S. aureus Long-time bactericidal effects No cytotoxicity vs. fibroblast cells | [95] | |
| Ti-pVAN | Surface-initiated atom transfer radical polymerization | S. aureus adhesion and colonization reduction | S. aureus adhesion and colonization reduction (∼20-fold) supported by VAN in mouse femurs canals in vivo model at 21 days | [96] | |
| MOF@Levo/LBL Ti foils | θ ≈ 27.5 ± 1.9° | Strong antibacterial effect vs. E. coli and S. aureus Osteoblasts adhesion and proliferation stimulation Early-stage (Runx2, ColI) and late-stage (OPN, OPC) osteogenic differentiation markers up-regulation | Osteointegration effect and antibacterial activity in rat model with S. aureus-infection | [92] | |
| GEN-BGS | Infection eradication (95.7%) Infection recurrence rate (4.3%) Bone void-filling (73.8%) | [89] | |||
| Innovative anti-microbial biomaterials | |||||
| HBD + BMP/HA-Ti | Dip-coating | BMP EE > 74% HBD-3 and BMP-2 synchronized slow, sustained release 40% up to 90% at 10 days | S. aureus and E. coli adhesion inhibition hBMSCs adhesion, proliferation, and osteogenic differentiation | [108] | |
| LL37- foils and wires | Simplified lyophilization method | θ ≈ 29.5 ± 3.9° LL37 sustained release within 7 d | S. aureus and MRSA proliferation inhibition Osteoinductive capabilities | Osteointegration capacities at 8 weeks in the femur of rat model S.aureus pre-infected | [109] |
| BMAP27(1–18)-coated Ti disks | Covalent binding | θ ≈ 68.3 ± 0.9° | S. epidermidis adhesion reduction No cytotoxic effects on osteoblast-like cells | [110] | |
| QK/AMP-coated Ti implant | Cu(I)-catalyzed azide-alkyne cycloaddition | S. aureus, E. coli, P. aeruginosa, and MRSA bactericidal effect (96.8%) HUVECs and hBMSCs adhesion, proliferation, angiogenic markers (VEGF and VEGFR-2), and osteogenic markers (ALP, ColI, RUNX-2, OPN, and OCN) up-regulation | Acute infection inhibition (99.63%), strong vascularization, and osseointegration promotion after 60 days’ implantation in rabbit bone (non-) infected with S. aureus | [111] | |
| BMI.ZnCl3-coated particles fillers for dental adhesive resin | Size up to 2 μm | S. mutants biofilm formation reduction No cytotoxic effects on dental pulp cells | [122] | ||
| PILs-based hydrogels | Inherent antibacterial effect (>70%) vs. Gram-negative/-positive bacteria Bactericidal effect (≥68.8%) vs. MRSA | [123] | |||
8. Conclusions
Author Contributions
Funding
Institutional Review Board Statement
Informed Consent Statement
Data Availability Statement
Acknowledgments
Conflicts of Interest
References
- Afari, M.E.; Syed, W.; Tsao, L. Implantable devices for heart failure monitoring and therapy. Heart Fail. Rev. 2018, 23, 935–944. [Google Scholar] [CrossRef] [PubMed]
- EMR Global Orthopaedic Implants Market: By Product: Plates and Screws, Nails and Rods, Pins and Wires; By Application; By End Use: Hospitals, Orthopaedic Clinics, Ambulatory Surgical Centres; Regional Analysis; Historical Market and Forecast (2016–2026); Mark. Available online: https://www.expertmarketresearch.com/reports/orthopaedic-implants-market (accessed on 1 March 2021).
- IMARC Cardiovascular Implants Market: Global Industry Trends, Share, Size, Growth, Opportunity and Forecast 2021–2026. Available online: https://www.imarcgroup.com/cardiovascular-implants-market (accessed on 1 March 2021).
- Navarro, M.; Michiardi, A.; Castaño, O.; Planell, J.A. Biomaterials in orthopaedics. J. R. Soc. Interface 2008, 5, 1137–1158. [Google Scholar] [CrossRef]
- Lam, M.T.; Wu, J.C. Biomaterial applications in cardiovascular tissue repair and regeneration. Expert Rev. Cardiovasc. Ther. 2012, 10, 1039–1049. [Google Scholar] [CrossRef]
- Wilson, J. Metallic biomaterials. In Fundamental Biomaterials: Metals; Elsevier: Amsterdam, The Netherlands, 2018; pp. 1–3. ISBN 9780081022054. [Google Scholar]
- Seebach, E.; Kubatzky, K.F. Chronic Implant-Related Bone Infections-Can Immune Modulation be a Therapeutic Strategy? Front. Immunol. 2019, 10, 1724. [Google Scholar] [CrossRef] [PubMed]
- Bai, D.; Chen, J.; Li, P.; Huang, W. Perspectives on Biomaterial-Associated Infection: Pathogenesis and Current Clinical Demands. In Racing for the Surface; Springer: Berlin/Heidelberg, Germany, 2020; pp. 75–93. [Google Scholar]
- Alexiou, K. Antibiotic prophylaxis in surgery. Surg. Chron. 2018, 11, 343–348. [Google Scholar]
- Ferraris, S.; Spriano, S. Antibacterial titanium surfaces for medical implants. Mater. Sci. Eng. C 2016, 61, 965–978. [Google Scholar] [CrossRef] [PubMed]
- Hall, T.J.; Villapún, V.M.; Addison, O.; Webber, M.A.; Lowther, M.; Louth, S.E.T.; Mountcastle, S.E.; Brunet, M.Y.; Cox, S.C. A call for action to the biomaterial community to tackle antimicrobial resistance. Biomater. Sci. 2020, 8, 4951–4974. [Google Scholar] [CrossRef] [PubMed]
- Milazzo, M.; Gallone, G.; Marcello, E.; Mariniello, M.D.; Bruschini, L.; Roy, I.; Danti, S. Biodegradable polymeric micro/Nano-structures with intrinsic antifouling/antimicrobial properties: Relevance in damaged skin and other biomedical applications. J. Funct. Biomater. 2020, 11, 60. [Google Scholar] [CrossRef] [PubMed]
- Romanò, C.L.; Tsuchiya, H.; Morelli, I.; Battaglia, A.G.; Drago, L. Antibacterial coating of implants: Are we missing something? Bone Jt. Res. 2019, 8, 199–206. [Google Scholar] [CrossRef]
- Abt, M.C.; Pamer, E.G. Commensal bacteria mediated defenses against pathogens. Curr. Opin. Immunol. 2014, 29, 16–22. [Google Scholar] [CrossRef]
- Moriarty, T.F.; Kuehl, R.; Coenye, T.; Metsemakers, W.J.; Morgenstern, M.; Schwarz, E.M.; Riool, M.; Zaat, S.A.J.; Khana, N.; Kates, S.L.; et al. Orthopaedic device-related infection: Current and future interventions for improved prevention and treatment. EFORT Open Rev. 2016, 1, 89–99. [Google Scholar] [CrossRef]
- Giles, C.; Lamont-Friedrich, S.J.; Michl, T.D.; Griesser, H.J.; Coad, B.R. The importance of fungal pathogens and antifungal coatings in medical device infections. Biotechnol. Adv. 2018, 36, 264–280. [Google Scholar] [CrossRef] [PubMed]
- Jamal, M.; Ahmad, W.; Andleeb, S.; Jalil, F.; Imran, M.; Nawaz, M.A.; Hussain, T.; Ali, M.; Rafiq, M.; Kamil, M.A. Bacterial biofilm and associated infections. J. Chin. Med. Assoc. 2018, 81, 7–11. [Google Scholar] [CrossRef] [PubMed]
- Muhammad, M.H.; Idris, A.L.; Fan, X.; Guo, Y.; Yu, Y.; Jin, X.; Qiu, J.; Guan, X.; Huang, T. Beyond Risk: Bacterial Biofilms and Their Regulating Approaches. Front. Microbiol. 2020, 11, 928. [Google Scholar] [CrossRef] [PubMed]
- Rajani, R.; Klein, J.L. Infective endocarditis: A contemporary update. Clin. Med. J. R. Coll. Phys. Lond. 2020, 20, 31–35. [Google Scholar] [CrossRef] [PubMed]
- Arciola, C.R.; Campoccia, D.; Montanaro, L. Implant infections: Adhesion, biofilm formation and immune evasion. Nat. Rev. Microbiol. 2018, 16, 397–409. [Google Scholar] [CrossRef]
- Benito, N.; Mur, I.; Ribera, A.; Soriano, A.; Rodríguez-Pardo, D.; Sorlí, L.; Cobo, J.; Fernández-Sampedro, M.; del Toro, M.; Guío, L.; et al. The Different Microbial Etiology of Prosthetic Joint Infections according to Route of Acquisition and Time after Prosthesis Implantation, Including the Role of Multidrug-Resistant Organisms. J. Clin. Med. 2019, 8, 673. [Google Scholar] [CrossRef]
- Pokrowiecki, R.; Mielczarek, A.; Zaręba, T.; Tyski, S. Oral microbiome and peri-implant diseases: Where are we now? Ther. Clin. Risk Manag. 2017, 13, 1529–1542. [Google Scholar] [CrossRef]
- Vila, P.M.; Ghogomu, N.T.; Odom-John, A.R.; Hullar, T.E.; Hirose, K. Infectious complications of pediatric cochlear implants are highly influenced by otitis media. Int. J. Pediatr. Otorhinolaryngol. 2017, 97, 76–82. [Google Scholar] [CrossRef]
- Becker, K.; Heilmann, C.; Peters, G. Coagulase-negative staphylococci. Clin. Microbiol. Rev. 2014, 27, 870–926. [Google Scholar] [CrossRef]
- Nappi, F.; Spadaccio, C.; Moon, M.R. A management framework for left sided endocarditis: A narrative review. Ann. Transl. Med. 2020, 8, 1627. [Google Scholar] [CrossRef] [PubMed]
- Mack, M.J.; Leon, M.B.; Smith, C.R.; Miller, D.C.; Moses, J.W.; Tuzcu, E.M.; Webb, J.G.; Douglas, P.S.; Anderson, W.N.; Blackstone, E.H.; et al. 5-year outcomes of transcatheter aortic valve replacement or surgical aortic valve replacement for high surgical risk patients with aortic stenosis (PARTNER 1): A randomised controlled trial. Lancet 2015, 385, 2477–2484. [Google Scholar] [CrossRef]
- Kapadia, S.R.; Leon, M.B.; Makkar, R.R.; Tuzcu, E.M.; Svensson, L.G.; Kodali, S.; Webb, J.G.; Mack, M.J.; Douglas, P.S.; Thourani, V.H.; et al. 5-year outcomes of transcatheter aortic valve replacement compared with standard treatment for patients with inoperable aortic stenosis (PARTNER 1): A randomised controlled trial. Lancet 2015, 385, 2485–2491. [Google Scholar] [CrossRef]
- Regueiro, A.; Linke, A.; Latib, A.; Ihlemann, N.; Urena, M.; Walther, T.; Husser, O.; Herrmann, H.C.; Nombela-Franco, L.; Cheema, A.N.; et al. Association between transcatheter aortic valve replacement and subsequent infective endocarditis and in-hospital death. JAMA J. Am. Med. Assoc. 2016, 316, 1083–1092. [Google Scholar] [CrossRef] [PubMed]
- Makkar, R.R.; Thourani, V.H.; Mack, M.J.; Kodali, S.K.; Kapadia, S.; Webb, J.G.; Yoon, S.-H.; Trento, A.; Svensson, L.G.; Herrmann, H.C.; et al. Five-Year Outcomes of Transcatheter or Surgical Aortic-Valve Replacement. N. Engl. J. Med. 2020, 382, 799–809. [Google Scholar] [CrossRef] [PubMed]
- Mack, M.J.; Leon, M.B.; Thourani, V.H.; Makkar, R.; Kodali, S.K.; Russo, M.; Kapadia, S.R.; Malaisrie, S.C.; Cohen, D.J.; Pibarot, P.; et al. Transcatheter Aortic-Valve Replacement with a Balloon-Expandable Valve in Low-Risk Patients. N. Engl. J. Med. 2019, 380, 1695–1705. [Google Scholar] [CrossRef] [PubMed]
- Reardon, M.J.; Van Mieghem, N.M.; Popma, J.J.; Kleiman, N.S.; Søndergaard, L.; Mumtaz, M.; Adams, D.H.; Deeb, G.M.; Maini, B.; Gada, H.; et al. Surgical or Transcatheter Aortic-Valve Replacement in Intermediate-Risk Patients. N. Engl. J. Med. 2017, 376, 1321–1331. [Google Scholar] [CrossRef]
- Lanz, J.; Kim, W.K.; Walther, T.; Burgdorf, C.; Möllmann, H.; Linke, A.; Redwood, S.; Thilo, C.; Hilker, M.; Joner, M.; et al. Safety and efficacy of a self-expanding versus a balloon-expandable bioprosthesis for transcatheter aortic valve replacement in patients with symptomatic severe aortic stenosis: A randomised non-inferiority trial. Lancet 2019, 394, 1619–1628. [Google Scholar] [CrossRef]
- Popma, J.J.; Deeb, G.M.; Yakubov, S.J.; Mumtaz, M.; Gada, H.; O’Hair, D.; Bajwa, T.; Heiser, J.C.; Merhi, W.; Kleiman, N.S.; et al. Transcatheter Aortic-Valve Replacement with a Self-Expanding Valve in Low-Risk Patients. N. Engl. J. Med. 2019, 380, 1706–1715. [Google Scholar] [CrossRef]
- Makkar, R.R.; Cheng, W.; Waksman, R.; Satler, L.F.; Chakravarty, T.; Groh, M.; Abernethy, W.; Russo, M.J.; Heimansohn, D.; Hermiller, J.; et al. Self-expanding intra-annular versus commercially available transcatheter heart valves in high and extreme risk patients with severe aortic stenosis (PORTICO IDE): A randomised, controlled, non-inferiority trial. J. Clean. Prod. 2020, 369, 669–683. [Google Scholar] [CrossRef]
- Mihos, C.G.; Nappi, F. A narrative review of echocardiography in infective endocarditis of the right heart. Ann. Transl. Med. 2020, 8. [Google Scholar] [CrossRef] [PubMed]
- Nappi, F.; Spadaccio, C.; Mihos, C.; Shaikhrezai, K.; Acar, C.; Moon, M.R. The quest for the optimal surgical management of tricuspid valve endocarditis in the current era: A narrative review. Ann. Transl. Med. 2020, 8, 1628. [Google Scholar] [CrossRef] [PubMed]
- Nappi, F.; Spadaccio, C.; Mihos, C. Infective endocarditis in the 21st century. Ann. Transl. Med. 2020, 8, 1620. [Google Scholar] [CrossRef] [PubMed]
- Nappi, F.; Singh, S.S.A.; Nappi, P.; Spadaccio, C.; Nenna, A.; Gentile, F.; Chello, M. Heart Valve Endocarditis. Surg. Technol. Int. 2020, 37, 203–215. [Google Scholar] [PubMed]
- Benedetto, U.; Spadaccio, C.; Gentile, F.; Moon, M.R.; Nappi, F. A narrative review of early surgery versus conventional treatment for infective endocarditis: Do we have an answer? Ann. Transl. Med. 2020, 8, 1626. [Google Scholar] [CrossRef] [PubMed]
- Mangner, N.; Woitek, F.; Haussig, S.; Schlotter, F.; Stachel, G.; Höllriegel, R.; Wilde, J.; Lindner, A.; Holzhey, D.; Leontyev, S.; et al. Incidence, Predictors, and Outcome of Patients Developing Infective Endocarditis Following Transfemoral Transcatheter Aortic Valve Replacement. J. Am. Coll. Cardiol. 2016, 67, 2907–2908. [Google Scholar] [CrossRef]
- Birt, M.C.; Anderson, D.W.; Bruce Toby, E.; Wang, J. Osteomyelitis: Recent advances in pathophysiology and therapeutic strategies. J. Orthop. 2017, 14, 45–52. [Google Scholar] [CrossRef] [PubMed]
- Arthritis Foundation Arthritis by the Numbers. Arthritis Found. 2019. Available online: https://www.arthritis.org/getmedia/e1256607-fa87-4593-aa8a-8db4f291072a/2019-abtn-final-march-2019.pdf (accessed on 1 March 2021).
- Tande, A.J.; Patel, R. Prosthetic joint infection. Clin. Microbiol. Rev. 2014, 27, 302–345. [Google Scholar] [CrossRef]
- Mombelli, A.; Müller, N.; Cionca, N. The epidemiology of peri-implantitis. Clin. Oral Implants Res. 2012, 23, 67–76. [Google Scholar] [CrossRef]
- Donlan, R.M. Biofilms: Microbial life on surfaces. Emerg. Infect. Dis. 2002, 8, 881–890. [Google Scholar] [CrossRef] [PubMed]
- Berne, C.; Ellison, C.K.; Ducret, A.; Brun, Y.V. Bacterial adhesion at the single-cell level. Nat. Rev. Microbiol. 2018, 16, 616–627. [Google Scholar] [CrossRef] [PubMed]
- Flemming, H.C.; Wingender, J. The biofilm matrix. Nat. Rev. Microbiol. 2010, 8, 623–633. [Google Scholar] [CrossRef] [PubMed]
- Colvin, K.M.; Irie, Y.; Tart, C.S.; Urbano, R.; Whitney, J.C.; Ryder, C.; Howell, P.L.; Wozniak, D.J.; Parsek, M.R. The Pel and Psl polysaccharides provide Pseudomonas aeruginosa structural redundancy within the biofilm matrix. Environ. Microbiol. 2012, 14, 1913–1928. [Google Scholar] [CrossRef] [PubMed]
- Nguyen, H.T.T.; Nguyen, T.H.; Otto, M. The staphylococcal exopolysaccharide PIA—Biosynthesis and role in biofilm formation, colonization, and infection. Comput. Struct. Biotechnol. J. 2020, 18, 3324–3334. [Google Scholar] [CrossRef]
- Subramani, R.; Jayaprakashvel, M. Bacterial Quorum Sensing: Biofilm Formation, Survival Behaviour and Antibiotic Resistance. In Implication of Quorum Sensing and Biofilm Formation in Medicine, Agriculture and Food Industry; Springer: Berlin/Heidelberg, Germany, 2019; pp. 21–37. [Google Scholar]
- Dhar, Y.; Han, Y. Current developments in biofilm treatments: Wound and implant infections. Eng. Regen. 2020, 1, 64–75. [Google Scholar] [CrossRef]
- Khatoon, Z.; McTiernan, C.D.; Suuronen, E.J.; Mah, T.F.; Alarcon, E.I. Bacterial biofilm formation on implantable devices and approaches to its treatment and prevention. Heliyon 2018, 4, e01067. [Google Scholar] [CrossRef] [PubMed]
- Hall, C.W.; Mah, T.F. Molecular mechanisms of biofilm-based antibiotic resistance and tolerance in pathogenic bacteria. FEMS Microbiol. Rev. 2017, 41, 276–301. [Google Scholar] [CrossRef]
- Li, B.; Webster, T.J. Bacteria antibiotic resistance: New challenges and opportunities for implant-associated orthopedic infections. J. Orthop. Res. 2018, 36, 22–32. [Google Scholar] [CrossRef]
- Dincer, S.; Uslu, F.M.; Delik, A. Antibiotic resistance in biofilm. In Bacterial Biofilms; IntechOpen: London, UK, 2020. [Google Scholar] [CrossRef]
- Rodis, N.; Tsapadikou, V.K.; Potsios, C.; Xaplanteri, P. Resistance Mechanisms in Bacterial Biofilm Formations: A Review. J. Emerg. Intern. Med. 2020, 4, 30. [Google Scholar]
- Boot, W.; Vogely, H.C. Prevention: Prophylaxis for implant-related infections: Current state of the art. In Management of Periprosthetic Joint Infection: A Global Perspective on Diagnosis, Treatment Options, Prevention Strategies and Their Economic Impact; Springer: Berlin/Heidelberg, Germany, 2017; pp. 108–120. ISBN 9783662544693. [Google Scholar]
- Ma, N.; Cameron, A.; Tivey, D.; Grae, N.; Roberts, S.; Morris, A. Systematic review of a patient care bundle in reducing staphylococcal infections in cardiac and orthopaedic surgery. ANZ J. Surg. 2017, 87, 239–246. [Google Scholar] [CrossRef] [PubMed]
- Spencer, M.P.; Christie, J. A 7 S Bundle Approach To Preventing Surgical Site Infections. Am. J. Infect. Control 2014, 42, S103. [Google Scholar] [CrossRef]
- Turner, N.A.; Sharma-Kuinkel, B.K.; Maskarinec, S.A.; Eichenberger, E.M.; Shah, P.P.; Carugati, M.; Holland, T.L.; Fowler, V.G. Methicillin-resistant Staphylococcus aureus: An overview of basic and clinical research. Nat. Rev. Microbiol. 2019, 17, 203–218. [Google Scholar] [CrossRef] [PubMed]
- Steffen, V.; Marsch, G.; Burgwitz, K.; Kuehn, C.; Teebken, O.E. Resistance to infection of long-term cryopreserved human aortic valve allografts. J. Thorac. Cardiovasc. Surg. 2016, 151, 1251–1259. [Google Scholar] [CrossRef] [PubMed]
- Kuehn, C.; Graf, K.; Mashaqi, B.; Pichlmaier, M.; Heuer, W.; Hilfiker, A.; Stiesch, M.; Chaberny, I.F.; Haverich, A. Prevention of early vascular graft infection using regional antibiotic release. J. Surg. Res. 2010, 164, e185–e191. [Google Scholar] [CrossRef] [PubMed]
- Zander, J.; Maier, B.; Zoller, M.; Döbbeler, G.; Frey, L.; Teupser, D.; Vogeser, M. Effects of biobanking conditions on six antibiotic substances in human serum assessed by a novel evaluation protocol. Clin. Chem. Lab. Med. 2016, 54, 265–274. [Google Scholar] [CrossRef]
- Nappi, F.; Nenna, A.; Petitti, T.; Spadaccio, C.; Gambardella, I.; Lusini, M.; Chello, M.; Acar, C. Long-term outcome of cryopreserved allograft for aortic valve replacement. J. Thorac. Cardiovasc. Surg. 2018, 156, 1357–1365. [Google Scholar] [CrossRef]
- Arabkhani, B.; Bekkers, J.A.; Andrinopoulou, E.R.; Roos-Hesselink, J.W.; Takkenberg, J.J.M.; Bogers, A.J.J.C. Allografts in aortic position: Insights from a 27-year, single-center prospective study. J. Thorac. Cardiovasc. Surg. 2016, 6, 1572–1579. [Google Scholar] [CrossRef] [PubMed]
- Nappi, F.; Spadaccio, C.; Chello, M.; Acar, C. The Ross procedure: Underuse or under-comprehension? J. Thorac. Cardiovasc. Surg. 2015, 149, 1463–1464. [Google Scholar] [CrossRef][Green Version]
- Alt, V. Antimicrobial coated implants in trauma and orthopaedics—A clinical review and risk-benefit analysis. Injury 2017, 48, 599–607. [Google Scholar] [CrossRef]
- Velic, A.; Hasan, J.; Li, Z.; Yarlagadda, P.K.D.V. Mechanics of Bacterial Interaction and Death on Nanopatterned Surfaces. Biophys. J. 2021, 120, 217–231. [Google Scholar] [CrossRef] [PubMed]
- Constantino, J.A.; Delgado-Rastrollo, M.; Pacha-Olivenza, M.A.; González-Martín, M.L.; Quiles, M.; Pérez-Giraldo, C.; Bruque, J.M.; Gallardo-Moreno, A.M. In vivo bactericidal efficacy of the Ti6Al4V surface after ultraviolet C treatment. J. Orthop. Traumatol. 2017, 18, 59–67. [Google Scholar] [CrossRef] [PubMed]
- Zhang, B.; Skelly, J.D.; Braun, B.M.; Ayers, D.C.; Song, J. Surface-Grafted Zwitterionic Polymers Improve the Efficacy of a Single Antibiotic Injection in Suppressing Staphylococcus aureus Periprosthetic Infections. ACS Appl. Bio Mater. 2020, 3, 5896–5904. [Google Scholar] [CrossRef]
- Buxadera-Palomero, J.; Albó, K.; Gil, F.J.; Mas-Moruno, C.; Rodríguez, D. Polyethylene glycol pulsed electrodeposition for the development of antifouling coatings on titanium. Coatings 2020, 10, 456. [Google Scholar] [CrossRef]
- Llopis-Grimalt, M.A.; Arbós, A.; Gil-Mir, M.; Mosur, A.; Kulkarni, P.; Salito, A.; Ramis, J.M.; Monjo, M. Multifunctional Properties of Quercitrin-Coated Porous Ti-6Al-4V Implants for Orthopaedic Applications Assessed In Vitro. J. Clin. Med. 2020, 9, 855. [Google Scholar] [CrossRef] [PubMed]
- Rifai, A.; Tran, N.; Reineck, P.; Elbourne, A.; Mayes, E.; Sarker, A.; Dekiwadia, C.; Ivanova, E.P.; Crawford, R.J.; Ohshima, T.; et al. Engineering the Interface: Nanodiamond Coating on 3D-Printed Titanium Promotes Mammalian Cell Growth and Inhibits Staphylococcus aureus Colonization. ACS Appl. Mater. Interfaces 2019, 11, 24588–24597. [Google Scholar] [CrossRef] [PubMed]
- Kalwar, K.; Shan, D. Antimicrobial effect of silver nanoparticles (AgNPs) and their mechanism—A mini review. Micro Nano Lett. 2018, 13, 277–280. [Google Scholar] [CrossRef]
- Forest, V.; Leclerc, L.; Hochepied, J.F.; Trouvé, A.; Sarry, G.; Pourchez, J. Impact of cerium oxide nanoparticles shape on their in vitro cellular toxicity. Toxicol. Vitr. 2017, 38, 136–141. [Google Scholar] [CrossRef]
- Li, X.; Qi, M.; Sun, X.; Weir, M.D.; Tay, F.R.; Oates, T.W.; Dong, B.; Zhou, Y.; Wang, L.; Xu, H.H.K. Surface treatments on titanium implants via nanostructured ceria for antibacterial and anti-inflammatory capabilities. Acta Biomater. 2019, 94, 627–643. [Google Scholar] [CrossRef]
- Ciobanu, G.; Harja, M. Cerium-doped hydroxyapatite/collagen coatings on titanium for bone implants. Ceram. Int. 2019, 45, 2852–2857. [Google Scholar] [CrossRef]
- Tran, P.A.; O’brien-Simpson, N.; Palmer, J.A.; Bock, N.; Reynolds, E.C.; Webster, T.J.; Deva, A.; Morrison, W.A.; O’connor, A.J. Selenium nanoparticles as anti-infective implant coatings for trauma orthopedics against methicillin-resistant Staphylococcus aureus and epidermidis: In vitro and in vivo assessment. Int. J. Nanomed. 2019, 14, 4613. [Google Scholar] [CrossRef]
- Yilmaz Atay, H. Antibacterial activity of chitosan-based systems. In Functional Chitosan: Drug Delivery and Biomedical Applications; Springer: Singapore, 2020; ISBN 9789811502637. [Google Scholar]
- Yang, Y.; Chu, L.; Yang, S.; Zhang, H.; Qin, L.; Guillaume, O.; Eglin, D.; Richards, R.G.; Tang, T. Dual-functional 3D-printed composite scaffold for inhibiting bacterial infection and promoting bone regeneration in infected bone defect models. Acta Biomater. 2018, 79, 265–275. [Google Scholar] [CrossRef] [PubMed]
- Jiao, Y.; Niu, L.; Ma, S.; Li, J.; Tay, F.R.; Chen, J. Quaternary ammonium-based biomedical materials: State-of-the-art, toxicological aspects and antimicrobial resistance. Prog. Polym. Sci. 2017, 71, 53–90. [Google Scholar] [CrossRef] [PubMed]
- Jennings, M.C.; Minbiole, K.P.C.; Wuest, W.M. Quaternary Ammonium Compounds: An Antimicrobial Mainstay and Platform for Innovation to Address Bacterial Resistance. ACS Infect. Dis. 2016, 1, 288–303. [Google Scholar] [CrossRef] [PubMed]
- Liu, L.; Peng, W.; Zhang, X.; Peng, J.; Liu, P.; Shen, J. Rational design of phosphonate/quaternary amine block polymer as an high-efficiency antibacterial coating for metallic substrates. J. Mater. Sci. Technol. 2021, 62, 96–106. [Google Scholar] [CrossRef]
- Bouloussa, H.; Saleh-Mghir, A.; Valotteau, C.; Cherifi, C.; Hafsia, N.; Cohen-Solal, M.; Court, C.; Crémieux, A.C.; Humblot, V. A Graftable Quaternary Ammonium Biocidal Polymer Reduces Biofilm Formation and Ensures Biocompatibility of Medical Devices. Adv. Mater. Interfaces 2021, 8, 2001516. [Google Scholar] [CrossRef]
- Song, J.; Winkeljann, B.; Lieleg, O. Biopolymer-Based Coatings: Promising Strategies to Improve the Biocompatibility and Functionality of Materials Used in Biomedical Engineering. Adv. Mater. Interfaces 2020, 7, 2000850. [Google Scholar] [CrossRef]
- Ständert, V.; Borcherding, K.; Bormann, N.; Schmidmaier, G.; Grunwald, I.; Wildemann, B. Antibiotic-loaded amphora-shaped pores on a titanium implant surface enhance osteointegration and prevent infections. Bioact. Mater. 2021, 6, 2331–2345. [Google Scholar] [CrossRef]
- Freischmidt, H.; Armbruster, J.; Reiter, G.; Grützner, P.A.; Helbig, L.; Guehring, T. Individualized techniques of implant coating with an antibiotic-loaded, hydroxyapatite/calcium sulphate bone graft substitute. Ther. Clin. Risk Manag. 2020, 16, 689–694. [Google Scholar] [CrossRef] [PubMed]
- Draghi, L.; Preda, V.; Moscatelli, M.; Santin, M.; Chiesa, R. Gentamicin-Loaded TiO2 Nanotubes as Improved Antimicrobial Surfaces for Orthopedic Implants. Front. Mater. 2020, 7, 233. [Google Scholar] [CrossRef]
- Ferguson, J.; Athanasou, N.; Diefenbeck, M.; McNally, M. Radiographic and Histological Analysis of a Synthetic Bone Graft Substitute Eluting Gentamicin in the Treatment of Chronic Osteomyelitis. J. Bone Jt. Infect. 2019, 4, 76–84. [Google Scholar] [CrossRef] [PubMed]
- McNally, M.A.; Ferguson, J.Y.; Lau, A.C.K.; Diefenbeck, M.; Scarborough, M.; Ramsden, A.J.; Atkins, B.L. Single-stage treatment of chronic osteomyelitis with a new absorbable, gentamicin-loaded, calcium sulphate/hydroxyapatite biocomposite: A prospective series of 100 cases. Bone Jt. J. 2016, 98, 1289–1296. [Google Scholar] [CrossRef] [PubMed]
- Pawar, V.; Bulbake, U.; Khan, W.; Srivastava, R. Chitosan sponges as a sustained release carrier system for the prophylaxis of orthopedic implant-associated infections. Int. J. Biol. Macromol. 2019, 134, 100–112. [Google Scholar] [CrossRef] [PubMed]
- Tao, B.; Zhao, W.; Lin, C.; Yuan, Z.; He, Y.; Lu, L.; Chen, M.; Ding, Y.; Yang, Y.; Xia, Z.; et al. Surface modification of titanium implants by ZIF-8@Levo/LBL coating for inhibition of bacterial-associated infection and enhancement of in vivo osseointegration. Chem. Eng. J. 2020, 390, 124621. [Google Scholar] [CrossRef]
- Masters, E.A.; Trombetta, R.P.; de Mesy Bentley, K.L.; Boyce, B.F.; Gill, A.L.; Gill, S.R.; Nishitani, K.; Ishikawa, M.; Morita, Y.; Ito, H.; et al. Evolving concepts in bone infection: Redefining “biofilm”, “acute vs. chronic osteomyelitis”, “the immune proteome” and “local antibiotic therapy”. Bone Res. 2019, 7, 20. [Google Scholar] [CrossRef] [PubMed]
- Ahmed, W.; Zhai, Z.; Gao, C. Adaptive antibacterial biomaterial surfaces and their applications. Mater. Today Bio 2019, 2, 100017. [Google Scholar] [CrossRef]
- Dwivedi, A.; Mazumder, A.; Nasongkla, N. Layer-by-layer nanocoating of antibacterial niosome on orthopedic implant. Int. J. Pharm. 2018, 547, 235–243. [Google Scholar] [CrossRef] [PubMed]
- Zhang, B.; Braun, B.M.; Skelly, J.D.; Ayers, D.C.; Song, J. Significant Suppression of Staphylococcus aureus Colonization on Intramedullary Ti6Al4V Implants Surface-Grafted with Vancomycin-Bearing Polymer Brushes. ACS Appl. Mater. Interfaces 2019, 11, 28641–28647. [Google Scholar] [CrossRef] [PubMed]
- Sinha, R.; Cámara-Torres, M.; Scopece, P.; Verga Falzacappa, E.; Patelli, A.; Moroni, L.; Mota, C. A hybrid additive manufacturing platform to create bulk and surface composition gradients on scaffolds for tissue regeneration. Nat. Commun. 2021, 12, 500. [Google Scholar] [CrossRef]
- Vargas-Alfredo, N.; Dorronsoro, A.; Cortajarena, A.L.; Rodríguez-Hernández, J. Antimicrobial 3D Porous Scaffolds Prepared by Additive Manufacturing and Breath Figures. ACS Appl. Mater. Interfaces 2017, 9, 37454–37462. [Google Scholar] [CrossRef]
- Milazzo, M.; Danti, S.; Inglese, F.; Jansen van Vuuren, G.; Gramigna, V.; Bonsignori, G.; De Vito, A.; Bruschini, L.; Stefanini, C.; Berrettini, S. Ossicular replacement prostheses from banked bone with ergonomic and functional geometry. J. Biomed. Mater. Res. Part B Appl. Biomater. 2017, 105, 2495–2506. [Google Scholar] [CrossRef] [PubMed]
- Milazzo, M.; Muyshondt, P.G.G.; Carstensen, J.; Dirckx, J.J.J.; Danti, S.; Buehler, M.J. De novo topology optimization of total ossicular replacement prostheses. J. Mech. Behav. Biomed. Mater. 2020, 103, 103541. [Google Scholar] [CrossRef] [PubMed]
- Feula, M.; Milazzo, M.; Giannone, G.; Azimi, B.; Trombi, L.; Cacopardo, L.; Moscato, S.; Lazzeri, A.; Ahluwalia, A.; Berrettini, S.; et al. Bioartificial Sponges for Auricular Cartilage Engineering. In Lecture Notes in Bioengineering; Springer: Berlin/Heidelberg, Germany, 2020; pp. 191–209. [Google Scholar]
- Milazzo, M.; Danti, S.; Inglese, F.; Berrettini, S.; Stefanini, C. Micro-machining of bovine bone for otologic applications. In Proceedings of the Euspen’s 18th International Conference & Exibition, Venice, Italy, 4–8 June 2018; pp. 1–2. [Google Scholar]
- Wang, J.; Dou, X.; Song, J.; Lyu, Y.; Zhu, X.; Xu, L.; Li, W.; Shan, A. Antimicrobial peptides: Promising alternatives in the post feeding antibiotic era. Med. Res. Rev. 2019, 39, 831–859. [Google Scholar] [CrossRef] [PubMed]
- Pinto, I.B.; dos Santos Machado, L.; Meneguetti, B.T.; Nogueira, M.L.; Espínola Carvalho, C.M.; Roel, A.R.; Franco, O.L. Utilization of antimicrobial peptides, analogues and mimics in creating antimicrobial surfaces and bio-materials. Biochem. Eng. J. 2019, 150, 107237. [Google Scholar] [CrossRef]
- Mahlapuu, M.; Björn, C.; Ekblom, J. Antimicrobial peptides as therapeutic agents: Opportunities and challenges. Crit. Rev. Biotechnol. 2020, 40, 978–992. [Google Scholar] [CrossRef] [PubMed]
- Raheem, N.; Straus, S.K. Mechanisms of Action for Antimicrobial Peptides With Antibacterial and Antibiofilm Functions. Front. Microbiol. 2019, 10, 2866. [Google Scholar] [CrossRef] [PubMed]
- Kazemzadeh-Narbat, M.; Cheng, H.; Chabok, R.; Alvarez, M.M.; de la Fuente-Nunez, C.; Phillips, K.S.; Khademhosseini, A. Strategies for antimicrobial peptide coatings on medical devices: A review and regulatory science perspective. Crit. Rev. Biotechnol. 2021, 41, 94–120. [Google Scholar] [CrossRef] [PubMed]
- Liu, H.W.; Wei, D.X.; Deng, J.Z.; Zhu, J.J.; Xu, K.; Hu, W.H.; Xiao, S.H.; Zhou, Y.G. Combined antibacterial and osteogenic in situ effects of a bifunctional titanium alloy with nanoscale hydroxyapatite coating. Artif. Cells Nanomed. Biotechnol. 2018, 46, S460–S470. [Google Scholar] [CrossRef] [PubMed]
- Shen, X.; Al-Baadani, M.A.; He, H.; Cai, L.; Wu, Z.; Yao, L.; Wu, X.; Wu, S.; Chen, M.; Zhang, H.; et al. Antibacterial and osteogenesis performances of LL37-loaded titania nanopores in vitro and in vivo. Int. J. Nanomed. 2019, 14, 3043. [Google Scholar] [CrossRef] [PubMed]
- Boix-Lemonche, G.; Guillem-Marti, J.; D’Este, F.; Manero, J.M.; Skerlavaj, B. Covalent grafting of titanium with a cathelicidin peptide produces an osteoblast compatible surface with antistaphylococcal activity. Colloids Surf. B Biointerfaces 2020, 185, 110586. [Google Scholar] [CrossRef]
- Chen, J.; Hu, G.; Li, T.; Chen, Y.; Gao, M.; Li, Q.; Hao, L.; Jia, Y.; Wang, L.; Wang, Y. Fusion peptide engineered “statically-versatile” titanium implant simultaneously enhancing anti-infection, vascularization and osseointegration. Biomaterials 2021, 264, 120446. [Google Scholar] [CrossRef] [PubMed]
- Pernak, J.; Rzemieniecki, T.; Materna, K. Ionic liquids “in a nutshell” (history, properties and development). Chemik 2016, 70, 471–475. [Google Scholar]
- Brunel, F.; Lautard, C.; di Giorgio, C.; Garzino, F.; Raimundo, J.M.; Bolla, J.M.; Camplo, M. Antibacterial activities of mono-, di- and tri-substituted triphenylamine-based phosphonium ionic liquids. Bioorg. Med. Chem. Lett. 2018, 28, 926–929. [Google Scholar] [CrossRef] [PubMed]
- Faisal, M.; Saeed, A. The role of ionic liquid in medicinal chemistry. In Green Approaches in Medicinal Chemistry for Sustainable Drug Design; Elsevier: Amsterdam, The Netherlands, 2020; p. 143. [Google Scholar]
- Prudêncio, C.; Vieira, M.; Van der Auweraer, S.; Ferraz, R. Recycling old antibiotics with ionic liquids. Antibiotics 2020, 9, 578. [Google Scholar] [CrossRef] [PubMed]
- Simões, M.; Pereira, A.R.; Simões, L.C.; Cagide, F.; Borges, F. Biofilm control by ionic liquids. Drug Discov. Today 2021. [Google Scholar] [CrossRef] [PubMed]
- Miskiewicz, A.; Ceranowicz, P.; Szymczak, M.; Bartuś, K.; Kowalczyk, P. The use of liquids ionic fluids as pharmaceutically active substances helpful in combating nosocomial infections induced by Klebsiella Pneumoniae new delhi strain, Acinetobacter Baumannii and Enterococcus species. Int. J. Mol. Sci. 2018, 19, 2779. [Google Scholar] [CrossRef] [PubMed]
- Gindri, I.M.; Palmer, K.L.; Siddiqui, D.A.; Aghyarian, S.; Frizzo, C.P.; Martins, M.A.P.; Rodrigues, D.C. Evaluation of mammalian and bacterial cell activity on titanium surface coated with dicationic imidazolium-based ionic liquids. RSC Adv. 2016, 6, 36475–36483. [Google Scholar] [CrossRef]
- Raucci, M.G.; Fasolino, I.; Pastore, S.G.; Soriente, A.; Capeletti, L.B.; Dessuy, M.B.; Giannini, C.; Schrekker, H.S.; Ambrosio, L. Antimicrobial Imidazolium Ionic Liquids for the Development of Minimal Invasive Calcium Phosphate-Based Bionanocomposites. ACS Appl. Mater. Interfaces 2018, 10, 42766–42776. [Google Scholar] [CrossRef]
- Fang, C.; Kong, L.; Ge, Q.; Zhang, W.; Zhou, X.; Zhang, L.; Wang, X. Antibacterial activities of N-alkyl imidazolium-based poly(ionic liquid) nanoparticles. Polym. Chem. 2019, 10, 209–218. [Google Scholar] [CrossRef]
- Muñoz-Bonilla, A.; Fernández-García, M. Poly(ionic liquid)s as antimicrobial materials. Eur. Polym. J. 2018, 105, 135–149. [Google Scholar] [CrossRef]
- Garcia, I.M.; Souza, V.S.; Souza, J.D.; Visioli, F.; Leitune, V.C.B.; Scholten, J.D.; Collares, F.M. Zinc-based particle with ionic liquid as a hybrid filler for dental adhesive resin. J. Dent. 2020, 102, 103477. [Google Scholar] [CrossRef] [PubMed]
- Claus, J.; Jastram, A.; Piktel, E.; Bucki, R.; Janmey, P.A.; Kragl, U. Polymerized ionic liquids-based hydrogels with intrinsic antibacterial activity: Modern weapons against antibiotic-resistant infections. J. Appl. Polym. Sci. 2021, 138, 50222. [Google Scholar] [CrossRef]

| MDIs | Implanted Devices | Microbial Strains Involved | Ref. |
|---|---|---|---|
| Cardiac | |||
| IE | Mechanical heart valves Ventricular shunts Cardiac electronic devices Endovascular stent | Staphylococci spp. (70%), Streptococci spp. (20%), Enterococci spp. (10%), HACEK bacteria group (3%) | [17,18,19] |
| Orthopaedic | |||
| OM | Joint replacement | Staphylococci (10–40%), CoNS (20–40%), Enterococci (3–7%), Pseudomonas (≈6%), E. coli (<3%) | [17,18,19,20,21] |
| PIJ | |||
| PI | Dental | P. gingivalis, A. actinomycetemcomitans, B. forsythus, T. denticola, P. nigrescens, P. micros, F. nucleatum (30–40%) | [22] |
| OTM | Cochlear | S. aureus, S. pneumoniae, H. influenzae, M. catarrhalis (1–12%) | [23] |
Publisher’s Note: MDPI stays neutral with regard to jurisdictional claims in published maps and institutional affiliations. |
© 2021 by the authors. Licensee MDPI, Basel, Switzerland. This article is an open access article distributed under the terms and conditions of the Creative Commons Attribution (CC BY) license (https://creativecommons.org/licenses/by/4.0/).
Share and Cite
Scialla, S.; Martuscelli, G.; Nappi, F.; Singh, S.S.A.; Iervolino, A.; Larobina, D.; Ambrosio, L.; Raucci, M.G. Trends in Managing Cardiac and Orthopaedic Device-Associated Infections by Using Therapeutic Biomaterials. Polymers 2021, 13, 1556. https://doi.org/10.3390/polym13101556
Scialla S, Martuscelli G, Nappi F, Singh SSA, Iervolino A, Larobina D, Ambrosio L, Raucci MG. Trends in Managing Cardiac and Orthopaedic Device-Associated Infections by Using Therapeutic Biomaterials. Polymers. 2021; 13(10):1556. https://doi.org/10.3390/polym13101556
Chicago/Turabian StyleScialla, Stefania, Giorgia Martuscelli, Francesco Nappi, Sanjeet Singh Avtaar Singh, Adelaide Iervolino, Domenico Larobina, Luigi Ambrosio, and Maria Grazia Raucci. 2021. "Trends in Managing Cardiac and Orthopaedic Device-Associated Infections by Using Therapeutic Biomaterials" Polymers 13, no. 10: 1556. https://doi.org/10.3390/polym13101556
APA StyleScialla, S., Martuscelli, G., Nappi, F., Singh, S. S. A., Iervolino, A., Larobina, D., Ambrosio, L., & Raucci, M. G. (2021). Trends in Managing Cardiac and Orthopaedic Device-Associated Infections by Using Therapeutic Biomaterials. Polymers, 13(10), 1556. https://doi.org/10.3390/polym13101556

